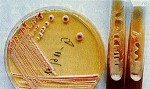
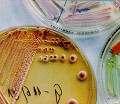

Az élet elkényeztetett gyermeke, gondolták az emberek az asszonyról, aki nem elég, hogy szép, még szépen is él a férjével. Anyagi biztonság, harmónia, sikerek – mindent megkapott az élettől.
![]() |
Ugyanez történt a nőgyógyászati panaszaival is. Először csak kis gond, amely nem akar gyógyulni, aztán a nagyobb baj, azzal sem tudtak mit kezdeni, mígnem következett a mindent lezáró műtét.
Támadás a mélyből
Bessenyei Odette betegségének és felépülésének történetét a könyvében olvastam. Azért írta, hogy megismertesse az emberekkel, különösen a nőkkel a candidiasis betegség, illetve a Candida gomba nevét és fogalmát. Hogy jelezze a veszélyt, amely szerinte mindannyiunkat, különösen a nőket fenyegeti. Ugyanezért hozott létre egy alapítványt is, és járja az országot, tart előadásokat, figyelmeztet, érvel, segít.
A Candida albicans bennünk élő gombaféle, amellyel mindaddig nincs gond, amíg a helytelen életmód következtében kórosan el nem szaporodik a szervezetben, és fel nem borítja az anyagcsere-folyamatokat.
– Ma már tudom, a velünk élő idős szülők halála volt az utolsó csepp a pohárban, ami végleg leterítette az én immunrendszeremet – mondja Bessenyei Odette, akinek harmincöt kilósan, a halálra készülődve került a kezébe egy ismertető a Candidáról. Ez vette rá, hogy a gyógyszereket félre, az ágyát pedig az erkélyre tolja, és kapszulák meg tabletták helyett inkább a napfény és a levegő gyógyító erejében bízzon.
– Ha valaki egészséges, világháborút, borzalmakat is túlél, de aki már legyengítette magát, annak nem kell sok, hogy leessen a lábáról. Engem ez a betegség tanított meg arra, hogy hiába van doktori címem, a legalapvetőbb dolgokat sem tudom magamról. Például azt, hogy mit kellene ennem, illetve, hogyan kellene élnem. Elsavasodott a szervezetem, ugyanúgy, mint a legtöbb emberé, csak idő kérdése volt, mikor omlik össze az egész. Nem töltöttem elég időt napon, levegőn, márpedig a gomba a sötét, nedves helyeket kedveli.
Egy szelet a tortából
![]() |
Az asszonynak, akinek a leveléből idézek, negyvenkét(!) féle gyógyszert írtak fel, ezek kiváltására havonta 48 112 forintot költhetne, ha győzné. „Nem tudom, hogyan tovább. Bármit eszem, semmi nem marad meg bennem, örökös hasmenésem van, és nagy fájdalmaim. És az az őrült végbélfájdalom, amelyet semmi nem csillapít. A kórházban lefogytam huszonkét kilóra, kómába is estem. Nem tudom, mi lesz velem.”
A Candidával foglalkozók szerint a betegek többsége nincs ilyen végletesen súlyos állapotban, lehet, hogy nem is látszanak betegnek egyáltalán. Ebből következően sokkal többen érintettek, mint gondolnánk. A legtöbbjüknek éppen csak kicsit hull a haja, fáradékony, miegymás. De hát ki nem az, gondolhatnánk, és gondolják is sokan. A tünetek sokfélék, a betegség több oldalról támad.
– Általános betegségérzet, fáradékonyság, levertség, memóriazavar, fejfájás, álmatlanság, édesség utáni vágy, hízás és sikertelen fogyókúra, puffadás, szelesedés, hasmenés vagy szorulás, viszketés, allergia, gyakori gyulladások, izom- és ízületi fájdalmak, hajhullás, gyermekeknél hiperaktivitás – sorolja dr. László Mária, aki hat-hét éve foglalkozik a gombás fertőzésben és allergiában szenvedő betegekkel.
Azt mondja, ha valaki a felsorolt panaszaival hiába járja az orvosokat, és a kivizsgálások mindig negatív eredménnyel zárulnak, akkor felmerül, hogy esetleg az elszaporodott gombák állnak a panaszok mögött. A mai ember életmódja nagyban hozzájárul a bennünk levő gombák elszaporodásához.
A nem megfelelő táplálkozás (sok édesség, fehér lisztből készült kenyér és pékáru, állati fehérje és zsiradék, félkész-, készételek, valamint kevés teljes értékű gyümölcs, zöldség, gabona és magvak fogyasztása) részben jó táptalajt biztosít a bennünk élő gombáknak, részben pedig vitamin, ásványi anyag és egyéb tápanyagok hiányához vezet.
Az antibiotikumok túlzott fogyasztása károsítja azokat a baktériumokat, melyek a belekben féken tartják a gombákat. A sok, fel nem oldott stressz és a szennyezett környezet gyengíti szervezetünk ellenálló képességét. Ha immunrendszerünk legyengül, nem tud védeni bennünket a vírusoktól, kórokozó baktériumoktól és gombáktól, valamint a különben is nap mint nap keletkező daganatos sejtektől.
A candidiázis diagnózisának felállítása nem könnyű feladat, hiszen a gombás fertőzést kereső kivizsgálások eredménye gyakran negatív. Ezért főleg az orvos ráérzése szükséges ahhoz, hogy a beteg megfelelő kezelésben részesüljön. Ez hosszadalmas, egyénre szabott, és a gombaölő gyógyszereken kívül megköveteli a beteg részéről az aktív közreműködést. Szükséges a diéta betartása, a bélflóra helyreállítása és a szervezet méregtelenítése.
Ok vagy tünet?
![]() |
– Fájt a fejem, zsibbadt az arcom. Először neurológushoz mentem, aki nyugtatót vagy pszichoterápiát javasolt. A könyv elolvasása után egyébként hiába ismertem rá a tünetekre, ez nem volt elég ahhoz, hogy komolyan is vegyem őket. Azt hiszem, sokan vannak ugyanígy. Akkoriban volt egy betegem, aki a hasonló tünetei mellett
súlyos depresszióval is küszködött. Egy teljesen egyszerű gyógyszeres kezelés gyökeresen változtatott mindkettőn. Akkor gondolkodtam el az összefüggéseken. Ez a kezelés rajtam is segített, de azt gondolom, ha a bajt a gyökerénél akarjuk orvosolni, valóban az életmódváltozás az alapvető megoldás. Úgy kell élni, hogy a gomba ne tudjon elszaporodni a szervezetben.
– Ebben az ügyben annyi izgalmas kérdés van, amelyet fel kellene tenni, kutatni kellene – mondja Palásthy doktornő. – Egy éve próbálom összerakni a mozaikokat, addig jutottam el én is, hogy a Candida nem oka, hanem tünete a szervezet anyagcserezavarának.
– A tünetek, a gomba jelenléte és a laboratóriumi eredmények között jelenleg nem bizonyított a teljes összefüggés, tehát nem lehet kijelenteni, hogy ezt mind a gomba okozza – mondja dr. Zala Judit mikológus, a Johan Béla Országos Epidemiológiai Központ osztályvezetője. – De az kétségtelen, hogy egyre több ember ismer rá magában ezekre a tünetekre, és az is, hogy a stressz, a környezetszennyezés és a helytelen táplálkozás miatt egyre gyengébb az emberek immunrendszere.
Hogy ezt a gomba okozza-e vagy éppen fordítva: erre a legyengült állapotra települ rá a gomba, ez amolyan tyúk-tojás probléma. Az is biztos, hogy az orvosok egy része azt mondja, ez nem Candida, és ezzel együtt az egész kérdést is elutasítja. Márpedig a jelenség létezik, nevezzük bárhogyan is, ez tény.
– Miért nem kutatják, vizsgálják?
– Mert ahhoz előbb le kellene győzni a problémával szembeni ellenállást, azt hiszem. Pedig fontos volna, hiszen úgy néz ki, hogy a mai diagnosztikai módszerek nem alkalmasak a kérdés feltárására. Annyi bizonyos, hogy életmódunk kedvez a gombák elszaporodásának és erre figyelnünk kellene. Az is valószínű, hogy ez a baj a mai gyerekek felnőtté válásakor fog tetőzni, hiszen ők elképesztő mennyiségű édességet és gyorsételt fogyasztanak. Az meg nem megnyugtató, hogy az orvosok, akikre talán a szükségesnél jobban is átterheljük a felelősséget a saját egészségünk felett, fontos dolgokat nem tudnak. Például nem tanítják meg őket az ételek alapos ismeretére, márpedig az „Étkezzen diétásan!” tanács önmagában kevés. Mindenkinek úgy és annyit kellene ennie, ahogy és amennyit neki kell. Csak neki. Ugyanúgy, mint az anyatejnél, hiszen ma már jól tudjuk, hogy nincs jó és rossz tej, sovány és zsíros, minden anya olyan tejet ad, amilyen az ő gyerekének kell.
– Nagyon óvatosan kell bánni a táplálkozási tanácsokkal – mondja dr. Zala Judit. – Nem lehet például a szénhidrátot teljesen megvonni, hiszen az az élet alapja, az energiaforrás, és ha a szervezet nem kap eleget, akkor máshonnan vonja el az előállításához szükséges anyagokat. Önmagában, azt hiszem, semmi sem tehető felelőssé. Az édességek sem. Gondoljunk csak a keleti kultúrákra, ahol mindent nagyon édesen esznek, még sincs ennyi beteg ember, mint nálunk. Mert ott van szieszta, nyugodtabb életritmus. Több tényezőn múlik az egyensúly, ez biztos.
Candida-ügyben nincs végszó, még a kérdések is kérdésesek. De talán nem kell feltétlenül tudományos válaszokban reménykednünk, hogy mérlegeljük, jó úton haladunk-e.
Hormon és felelősség
A Candida elsősorban a nőket fenyegeti, de fertőző, így a férfiak sincsenek védve tőle. Van, aki szerint hormonális okok miatt támadja a nőket, mások szerint a mi testfelépítésünk kedvezőbb egy gombásodási folyamat számára. Az is lehet, hogy az egésznek más oka van. Érdemes elgondolkodni azon, mennyire a nőkön múlik az, hogy a családok hogyan élnek. Hogy mi kerül az asztalra, hogy mire mennyit költenek. Ha változtatnunk kell – márpedig kell, erre egyre több jel figyelmeztet –, nem a nők-e azok, akik ezt megtehetik? Ez persze, nem valami tudományos magyarázat, de Candida-ügyben tudományos magyarázatból van a legkevesebb.
Alapítvány és klub
•A Candida Egészség Alapítvány telefonszáma: 386-9708
Levélcím: 1113 Budapest, Daróczi u. 27. Internet: www.webexpress.hu
•A Candida Klub (Kispest) telefonszáma: 281-3035